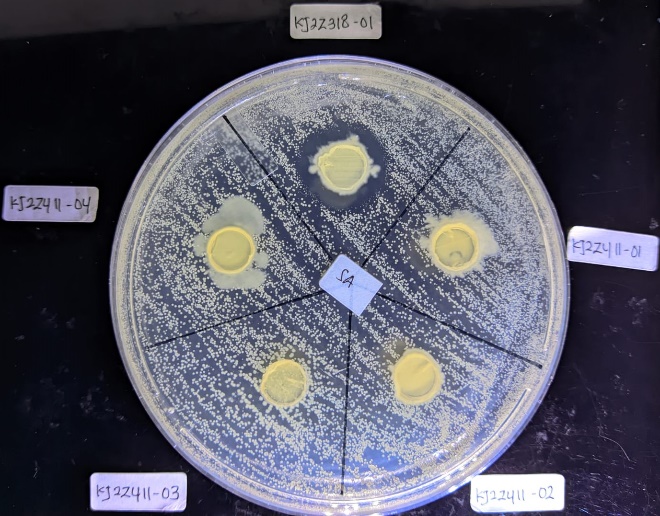
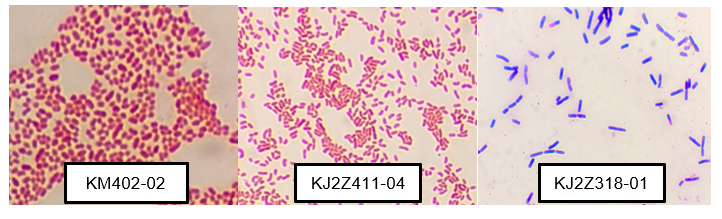

Trends
Sci.
2025; 22(10): 10472
Screening of Antibacterial Compound and Detection of Polyketide Synthetase - Non Ribosomal Peptide Synthetase (PKS-NRPS) Biosynthetic Gene from Tunicates-Associated Bacteria Collected from The Kumbang Shipwreck (Karimunjawa, Indonesia)
Robby Maulana Putra1,3, Diah Ayuningrum2,*, Aninditia Sabdaningsih2 and Atika Arifati2
1Postgraduate Program of Aquatic Resources Management Department of Aquatic Resources,
Faculty of Fisheries and Marine Sciences, Universitas Diponegoro, Semarang 50275, Indonesia
2Department of Aquatic Resources, Faculty of Fisheries and Marine Sciences, Universitas Diponegoro,
Semarang 50275, Indonesia
3Fisheries Science Department, Faculty of Agricultural, Universitas Sultan Ageng Tirtayasa, Serang 42163, Indonesia
(*Corresponding author’s e-mail: [email protected])
Received: 25 April 2025, Revised: 19 May 2025, Accepted: 26 May 2025, Published: 30 July 2025
Abstract
The presence of bacteria resistant to various types of antibiotics referred to as MDR (Multi Drugs Resistant) bacteria has driven the exploration of bioactive compounds as new antibiotic candidates. Tunicates-associated bacteria have been reported to have the potential to produce bioactive compounds that can fight MDR bacteria. This study aims to isolate and analyze the number of colonies of tunicate-associated bacteria on different media, analyze the antibacterial activity of isolates against MDR bacteria, find potential tunicate-associated bacterial species in inhibiting MDR bacteria, and detect PKS-1 and NRPS genes from potential isolates. The methods used were isolation of associated bacteria by multistage dilution method, screening of antibacterial activity using agar plug method, amplification of 16S rRNA, PKS-1 and NRPS genes using Polymerase Chain Reaction (PCR) method, and species identification by 16S rRNA gene sequencing then analyzed using Basic Local Alignment Search Tool (BLAST). The results were obtained tunicates from the Genera Polycitorella, Plebobranchia, Rhopalaea, Clavelina, and Didemnum. Pure isolates that were successfully isolated from the 6 tunicates were 12 isolates from Zobell 2216 media and 69 isolates from M1 media. Potential isolates obtained include isolate KM402-02 which is Klebsiella variicola (homology 99.20%) able to inhibit S. aureus (3.3 mm), E. coli (5.8 mm) and P. aeruginosa (4.6 mm), isolate KJ2Z411-04 is Vibrio alginolytiicus (homology 99.86%) able to inhibit S. aureus (10 mm) and E. coli (8.4 mm), and isolate KJ2Z318-01 is Bacillus paramycoides (homology 99.86%) able to inhibit S. aureus (7.8 mm) and E. coli (4.1 mm). Isolation using M1 media showed better results on the growth of tunicates association bacteria. This study succeeded in identifying 3 potential bacteria as anti-MDR. PKS-1 gene was detected in Klebsiella variicola and Vibrio alginolytiicus.
Keywords: Antibacterial, MDR bacteria, Tunicate, PKS genes, NRPS genes
Introduction
Antibiotic resistance in bacteria develops as a consequence of unnecessary and improper antibiotic use. The diversity in bacterial classifications, patterns of pathogen sensitivity, and the continuous discovery of new antibiotics complicate the selection of appropriate antibiotics for treating diseases, thereby potentiallyfostering bacterial resistance [1]. The ability of bacteria to counteract antibacterial agents can lead to the formation of Multi-Drug Resistant (MDR) bacterial strains, resistant to multiple antibiotic types. The emergence of diseases caused by resistant bacteria has driven the exploration of new drugs, though resistance to these drugs often develops rapidly [2], limiting the available options for effectively combating infections caused by MDR bacteria, such as Pseudomonas aeruginosa, Methicillin-Resistant Staphylococcus aureus (MRSA), Escherichia coli, Acinetobacter baumannii, Klebsiella pneumoniae, among others [3]. This challenge underscores the need for exploring bioactive compounds as potential candidates for new antibiotics against MDR bacterial infections.
Indonesia’s rich marine biodiversity offers a promising source of bioactive compounds. Marine Natural Products (MNPs) accumulate in marine invertebrates such as sponges, tunicates, bryozoans, and mollusks [4]. Tunicates, in particular, host a wide variety of symbiotic microorganisms due to their unique filtration and digestive systems [5]. Symbiotic microorganisms isolated from tunicates include members of the Bacteria, Archaea, and Fungi groups, with bacteria being the most abundant and diverse [6]. Bioactive compounds produced by tunicates and their bacterial symbionts exhibit antibacterial properties; these include Patelazole C & D, Clavanin, Halocyntin & Papilopsin, Halocidin [7], and Crucidasterin [8]. In Indonesia, tunicates and their associated bacteria remain an underexplored bioresource [9]. The potential of tunicates-associated bacteria as producers of antibacterial compounds increases the likelihood of discovering bioactive compounds capable of combating pathogenic MDR bacteria in humans. The production of bioactive compounds by bacteria is influenced by environmental factors such as temperature, pH, media composition, and fermentation duration. Small changes in media composition can significantly impact the quality and quantity of secondary metabolite production, as well as the organism’s overall metabolic balance [10].
Secondary metabolites are typically synthesized by enzymes encoded within biosynthetic gene clusters (Biosynthetic Gene Clusters, BGC), including PKS (polyketide synthases) and NRPS (non-ribosomal peptide synthetases) genes. A range of polyketides and peptides used in pharmaceuticals, agriculture, and biochemistry - including antibiotics (penicillin, vancomycin, and erythromycin), antifungals (nystatin), antitumor (ansamitocin, bleomycin), and immunosuppressants (rapamycin) - are synthesized by type-I PKS (PKS-1) and NRPS [11]. The synthesis of secondary metabolites is often a response to specific environmental conditions, and BGCs may be expressed at low levels in laboratory conditions, resulting in metabolites that fall below analytical detection thresholds [12]. Consequently, the detection of PKS-1 and NRPS genes can serve as an initial indicator of the potential for secondary metabolites within the genome of tunicate-associated bacteria, contributing to the discovery of bioactive compounds as candidates for new antibiotics.
Materials and methods
Sample collection
The ascidian sample was collected from Kumbang Shipwreck located at a depth of 12 - 20 m using SCUBA Diving gear. The sampling point was in coordinate 5 46'22.05"S and 110 14'28.05"E. The ascidian sample was collected randomly, put in sterile Ziplock plastic with its surrounding seawater, and then put the Ziplock plastic inside the cool box for further processing in the Laboratory.
Isolation and purification
Isolation of ascidian-associated bacteria was using serial dilution and spread method, meanwhile, the purification was based on the morphology of the colony. Tunicate tissue ad much as 1 g was grinded and diluted in stages, 30 µL of 103 and 104 dilutions were spread on the surface of Zobell 2216 (40,25 g of Zobell powder and 15 g of agar into 1 L seawater) and M1(10 g of starch, 4 g of yeast extract, 2 g of peptones, 15 g of agar into 1 L seawater) media that had been added with 25 mg/L nystatin, then incubated for 2 days at room temperature [9]. The colonies bacteria that grow were separated based on differences in colony morphology using streak method on the same media from isolation. This method was conducted in [13].
Screening of anti-MDR activity
Antibacterial activity screening was conducted using the plug agar method [14]. A loopful of each MDR bacteria strain (E. coli, S. aureus, and P. aeruginosa) was transferred to NB medium and shaken overnight at 120 rpm. The overnight MDR bacterial culture (approximately 20 h) was then diluted with sterile distilled water to turbidity matching the 0.5 McFarland standard, equivalent to 1×108 CFU/mL. The 0.5 McFarland bacterial suspension was spread onto the surface of the MHA medium using a cotton swab. Overnight cultures of bacterial isolates on M1 or Zobell medium were punctured with a sterile blue microtip and then placed onto the surface of the MHA medium that had been swabbed with MDR bacteria. Antagonistic testing of the bacteria was performed in duplicate and incubated at 37 C. Antibacterial activity was indicated by the formation of an inhibition zone (clear zone) on the test medium. The clear zone diameter was measured using calipers after 24 h and again at 48 h.
Identification of potential isolates
Morphological identification
The morphological characterization of potential isolates was performed by observing colony morphology and conducting Gram staining, based on [15]. Colony observations included configuration, margin, elevation, and color. Gram staining was conducted before microscopic observation to determine bacterial cell shape and Gram reaction.
Molecular identification
Bacteria demonstrating antagonistic activity against MDR bacterial growth were subsequently identified using molecular methods. DNA extraction from tunicate-associated bacteria followed the Quick-DNA™ Fungal/Bacterial Miniprep Kit protocol. The extracted DNA was then amplified by PCR using universal primers 27F (5’-AGAGTTTGATCMTGGCTCAG-3’) and 1492R (5’-GGTTACCTTGTTACGACTT-3’) to obtain the 16S rDNA sequence. The PCR mixture consisted of 2 µL DNA template, 1 µL primer 27F, 1 µL primer 1492R, 8.5 µL ddH2O, and 12.5 µL GoTaq Green Master Mix, resulting in a total volume of 25 µL. Amplification was carried out with a BIO-RAD T100 Thermal Cycler. The PCR conditions used in this study were as follows: Initial denaturation at 95 C for 3 min, followed by 30 cycles of denaturation at 95 C for 1 min, annealing at 54 C for 1 min, and extension at 72 C for 1 min 30 s, with a final extension at 72 C for 7 min [14]. The DNA amplification results were observed using gel electrophoresis. A 1 % agarose gel was prepared by dissolving 1 %w/v agarose in 1X TBE buffer using a microwave. While in the liquid phase (warm temperature), 1% agarose was mixed with Gel Green Nucleic Acid Stain (as an alternative to EtBr) before pouring into the mold. The 16S rRNA PCR products and a DNA marker, each 3 µL, were mixed with 2 µL of loading dye and loaded into the wells of the 1% agarose gel submerged in 1X TBE buffer solution. Electrophoresis was conducted at 100 V for 30 min, and the gel was visualized using a gel documentation system.
BLAST homology and phylogenetic tree
The 16S rRNA PCR products were sent to PT Genetika Science (Jakarta, Indonesia) for 16S rRNA gene sequencing. The obtained sequences were analyzed using MEGA 11 software to perform BLAST homology, generating results in FASTA format, which were then compared with the GenBank database to identify nucleotide sequence similarity and determine the bacterial species obtained. Regions with sequence similarity were further analyzed using the Basic Local Alignment Tool (BLAST) to determine the percentage of base-pair similarity with reference isolates in the gene bank. A phylogenetic tree was constructed using Neighbor-Joining analysis [16] and evaluated by the bootstrap method. Phylogenetic analysis was conducted with MEGA 11 to identify the bacterial species obtained, and bacterial sequences were aligned using the ClustalW program.
Detection of PKS-NRPS gene
The amplification of the PKS-I gene was conducted using the primers K1F (5’-TSAAGTCSAACATCGGBCA-3’) and M6R (5’-CGCAGGTTSCSGTACCAGTA-3’), while the NRPS gene was amplified using the primers A3F (5’-GCSTACSYSATSTACACSTCSGG-3’) and A7R (5’-SASGTCVCCSGTSCGGTAS-3’). The PCR mix used for amplifying the PKS-I and NRPS genes consisted of 2 µL DNA template, 1 µL forward primer, 1 µL reverse primer, 8.5 µL ddH2O, and 12.5 µL GoTaq Red Master Mix, resulting in a total volume of 25 µL. Amplification was performed using a BIO-RAD T100 Thermal Cycler. The PCR conditions used in this study, optimized according to Tomaseto et al. [17], were as follows: Initial denaturation at 95 C for 5 min, followed by 35 cycles of denaturation at 95 C for 1 min, annealing at 50 C for the PKS-I gene and at 60 C for the NRPS gene for 1 min, and extension at 72 C for 1 min, with a final extension at 72 C for 7 min. The presence of the PKS-I and NRPS genes was confirmed by DNA gel electrophoresis, where the PKS-I gene aligned with a DNA ladder band at 1,100 base pairs (bp), and the NRPS gene aligned with a band at 800 bp.
Results and discussion
Isolation and purification
Bacterial colonies growing on the agar surface were characterized based on differences in colony morphology including configuration, margin, elevation, and color. The total number of colonies that grew on the surface of the media was 111 colonies, including 29 colonies on Zobell 2216 media and 82 colonies on M1 media. Purification of bacterial colonies generated 81 isolates, including 12 isolates from Zobell 2216 media and 69 isolates from M1 media [13].
Screening of anti-MDR activity
Antibacterial tests were carried out on 81 isolates against 3 MDR bacteria, and 25 active isolates were obtained which were characterized by the formation of inhibition zones around the agar pieces (Figure 1), Inhibition zone measurements can be seen in Table 1, and some anti-MDR isolates for each test can be seen in (Figure 2).
Table 1 Zone of inhibition (ZOI) measurements.
No |
Isolate code |
ZOI (mm) |
||||||||||||||
S. aureus |
E. coli |
P. aeruginosa |
||||||||||||||
I |
II |
III |
IV |
V |
I |
II |
III |
IV |
V |
I |
II |
III |
IV |
V |
||
1 |
KM302-01 |
3,4 |
- |
- |
- |
- |
- |
- |
- |
- |
- |
- |
- |
- |
- |
- |
2 |
KM402-01 |
+ |
- |
- |
- |
- |
+ |
- |
- |
- |
- |
- |
- |
- |
- |
- |
3 |
KM402-02 |
+ |
1,7 |
- |
- |
3,1 |
5,8 |
3,3 |
- |
- |
1,6 |
+ |
+ |
- |
- |
4,6 |
4 |
KM402-03 |
+ |
1,8 |
- |
- |
- |
6,3 |
- |
- |
- |
- |
+ |
4,7 |
- |
- |
2,3 |
5 |
KM402-05 |
- |
- |
- |
- |
- |
+ |
- |
- |
- |
- |
+ |
- |
- |
- |
- |
6 |
KM315-01 |
- |
- |
- |
- |
- |
- |
- |
- |
- |
- |
+ |
4,9 |
- |
- |
+ |
7 |
KM415-01 |
1,3 |
- |
- |
- |
- |
- |
- |
- |
- |
- |
- |
- |
- |
- |
- |
8 |
KM415-02 |
2,6 |
- |
- |
- |
- |
- |
- |
- |
- |
- |
- |
- |
- |
- |
- |
9 |
KM318-02 |
+ |
- |
- |
- |
- |
+ |
- |
- |
- |
- |
- |
- |
- |
- |
- |
10 |
KM318-03 |
1,3 |
- |
- |
- |
- |
- |
- |
- |
- |
- |
- |
- |
- |
- |
- |
11 |
KM318-05 |
+ |
- |
- |
- |
- |
- |
- |
- |
- |
- |
- |
- |
- |
- |
- |
12 |
KM418-06 |
- |
- |
- |
- |
- |
+ |
- |
- |
- |
- |
- |
- |
- |
- |
- |
13 |
KM418-07 |
1,2 |
- |
- |
- |
3,6 |
- |
- |
- |
- |
- |
- |
- |
- |
- |
- |
14 |
KM418-08 |
2,2 |
- |
- |
- |
- |
- |
- |
- |
- |
- |
- |
- |
- |
- |
- |
15 |
KM418-11 |
2,7 |
+ |
- |
- |
- |
- |
+ |
- |
- |
- |
- |
- |
- |
- |
- |
16 |
KM325-02 |
- |
- |
- |
- |
- |
- |
3,6 |
- |
- |
- |
+ |
3,3 |
- |
- |
+ |
17 |
KM325-04 |
+ |
- |
- |
- |
- |
+ |
3,2 |
- |
- |
- |
- |
- |
- |
- |
- |
18 |
KM425-07 |
- |
- |
- |
- |
- |
+ |
- |
- |
- |
- |
- |
- |
- |
- |
- |
19 |
KM425-08 |
- |
- |
- |
- |
- |
+ |
- |
- |
- |
- |
- |
- |
- |
- |
- |
20 |
KJ2Z302-05 |
+ |
- |
- |
- |
- |
- |
- |
- |
- |
- |
- |
- |
- |
- |
- |
21 |
KJ2Z411-01 |
- |
- |
- |
- |
- |
- |
- |
- |
- |
- |
+ |
- |
- |
- |
- |
22 |
KJ2Z411-02 |
- |
- |
- |
- |
- |
+ |
- |
- |
- |
- |
+ |
- |
- |
- |
- |
23 |
KJ2Z411-03 |
- |
- |
- |
- |
- |
- |
- |
- |
- |
- |
+ |
- |
- |
- |
- |
24 |
KJ2Z411-04 |
+ |
10 |
- |
- |
8,8 |
+ |
8,4 |
- |
- |
- |
- |
- |
- |
- |
- |
25 |
KJ2Z318-01 |
5,1 |
5,4 |
- |
6,2 |
5,3 |
+ |
2,3 |
- |
4,1 |
4,8 |
- |
- |
- |
- |
- |
Description: + (ZOI less than 1 mm), - (ZOI = 0), KM (isolated from M1 media), 3 (dilution 10 - 3) 02 (number of the sample) –01 (number of isolates), KJ2Z (isolated from Zobell media), 4 (dilution 10 - 4) 11 (number of the sample) –04 (number of isolates).
Figure 1 Inhibition zone from active isolate against MDR bacteria.

Figure 2 Number of anti-MDR isolates for each test. X = number of test of MDR bacteria (S. aureus, E. coli, P.aeruginosa), y = number of active isolates.
Antagonistic tests were conducted 5 times to determine the ability of isolates from the initial generation to the next generation and after storage in the freezer. Tests I and II were conducted before the isolates were preserved at –80 C, while tests III, IV, and V were conducted after being stored in the freezer at –80 C. Table 1 shows the potential of tunicates-associated bacteria in producing growth inhibition of MDR bacteria, namely in the test I obtained 25 active isolates. Active isolates in test I (1st generation) were tested again to determine the ability of the 2nd generation in test II, there was a decrease in the number of active isolates, leaving 8 active isolates. Test III was conducted on isolates that had been stored in a –80 C freezer, then grown on Zobell and M1 media to obtain the 3rd generation. Test III showed negative results on all isolates that were active in test I. The 4th generation of active isolates carried out test IV for confirmation of test III, the result is only 1 isolate that shows antibacterial activity, namely isolate with code KJ2Z310-01. The last confirmation was carried out in test V, which obtained 6 isolates that showed antibacterial activity, namely isolates with the code KM402-02, KM402-03, KM315-01, KM325-02, KJ2Z318-01, and KJ2Z318-01.
Figure 2 shows a decrease in the number of active isolates in each test. Active isolates that showed inhibition against S. aureus amounted to 16 isolates in test I, 5 isolates in test II, 1 isolate in test IV, and 4 isolates in test V. The number of active isolates that can inhibit E. coli includes 12 isolates in test I, 6 isolates in test II, and 2 isolates in test V. The number of active isolates in inhibiting P. aeruginosa has also decreased including 8 isolates in test I, 4 isolates in test II, and 4 isolates in test V.
Identification of potential isolates
Potential isolates were selected based on the consistency of their antibacterial activity with the best inhibition zone and measured during 5 tests including KM402-02, KJ2Z411-04, and KJ2Z318-01. Potential bacterial isolates were identified for cell morphology by Gram staining and species identification based on the 16S rRNA gene. Gram staining is conducted to determine the shape and Gram of the bacterial isolate. Figure 3 shows that isolate KM402-02 is a Gram-negative bacillus, KJ2Z411-04 is a Gram-negative bacillus (slightly bent), and isolate KJ2Z318-01 is a Gram-positive bacillus. The Gram-positive bacteria often produce Lantibiotics (e.g., nisin), bacteriocins, polyketides. Produce larger peptides (like lantibiotics) that can’t easily cross the outer membrane of Gram-negatives. Meanwhile Gram-negative bacteria produce Siderophores (e.g., pyoverdine), bacteriocins (e.g., colicins), non-ribosomal peptides. Produce smaller, membrane-permeable molecules (e.g., quinolones, phenazines) [48,49].
Figure 3 Microscopic observation with magnification 1,000 X of isolates KM402-02 (Gram-negative bacillus), KJ2Z411-04 (Gram-negative bacillus), and KJ2Z318-01 (Gram-positive bacillus) during the incubation period of 1×24 h.
Identification of potential bacterial species based on the 16S rRNA gene begins with bacterial DNA extraction, 16S rRNA gene amplification, 16S rRNA amplicons sequencing, analysis using BLAST, and then phylogenetic tree construction. Based on amplifying the 16S rRNA gene, the results showed that the resulting DNA band showed a size of 1,500 bp, according to the desired DNA target length. The visualization results of DNA bands can be seen in Figure 4.

Figure 4 DNA band visualization results from 16S rRNA gene amplification revealed 1,500 bp for all isolates.
BLAST analysis shows the percentage similarity of potential isolate sequences with bacterial sequence data in gene banks (Table 2). BLAST search results showed that isolate KM402-02 had a percent identity (Per.Ident) value of 99.20% with Klebsiella variicola strain F2R9, isolate KJ2Z411-04 had a per.ident of 99.86 % with Vibrio alginolyticus strain ATCC 17749, and isolate KJ2Z318-01 had a per.ident of 99.89% with Bacillus paramycoides strain MCCC 1A04098. The results of BLAST analysis can also be used to select recommendations for comparative bacterial species in phylogenetic tree construction.
Table 2 Results of DNA sequence analysis with BLAST.
Isolate code |
Sort |
Description |
Query Cover |
Per.Ident |
Accession |
KM402-02 |
1 |
Klebsiella variicola strain F2R9 |
100% |
99.20% |
NR_025635.1 |
|
2 |
Klebsiella pneumoniae strain JCM1661 |
100% |
98.91% |
NR_112009.1 |
|
3 |
Klebsiella pneumoniae strain DSM 30104 |
100% |
98.91% |
NR_036794.1 |
KJ2Z411-04 |
1 |
Vibrio alginolyticus strain ATCC 17749 |
100% |
99.86% |
NR_118258.1 |
|
2 |
Vibrio alginolyticus strain NBRC 15630 |
99% |
99.72% |
NR_113781.1 |
|
3 |
Vibrio alginolyticus strain ATCC 17749 |
99% |
99.72% |
NR_117895.1 |
KJ2Z318-01 |
1 |
Bacillus paramycoides strain MCCC 1A04098 |
100% |
99.86% |
NR_157734.1 |
|
2 |
Bacillus tropicus strain MCCC 1A01406 |
100% |
99.78% |
NR_157736.1 |
|
3 |
Bacillus nitratireducens strain MCCC 1A00732 |
100% |
99.78% |
NR_157732.1 |
Phylogenetic tree of potential isolates
Phylogenetic tree construction aims to determine the level of kinship of tunicates-associated bacterial isolates with other bacteria. The results of phylogenetic tree construction using MEGA 11 application (Figure 5) show that isolate KM402-02 is Klebsiella variicola strain F2R9 with a bootstrap value of 97, closely related to Klebsiella pneumoniae strain DSM 30104, and is in the same clade as Enterobacter cloacae. Isolate KJ2Z411-04 is Vibrio alginolyticus strain ATCC 17749 with a bootstrap value of 100, closely related to Vibrio natriegens NBRC 15636 with a bootsrap of 99, and is in the same clade as Vibrio campbellii strain NBRC 15631 and Vibrio rotiferianus strain CAIM 577. Isolate KJ2Z318-01 is Bacillus paramycoides strain MCCC 1A04098 with a bootstrap value of 97 and has a kinship with Bacillus marcorestinctum strain LQQ. Streptomyces griseorubens strain JSD-1 is a group of Actinobacteria selected as an outgroup in the construction of phylogenetic trees.

Figure 5 Construction of phylogenetic tree with neighbor-joining. Isolates KM402-02, KJ2Z411-04, and KJ2Z318-01 are tunicate-associated bacteria that have antibacterial activity with the outgroup Streptomyces griseorubens.
Detection of PKS-NRPS gene
The amplification results of PKS-1 and NRPS genes were confirmed using gel electrophoresis. The PKS-1 gene has a size of 1,100 bp, while the NRPS gene is 800 bp. PKS-1 gene detection of 3 potential isolates can be seen in Figure 6. The visualization results of the PKS-1 gene band show the appropriate base length of ± 1,100 bp compared to the 1 kb DNA ladder. PKS-1 gene was successfully detected in Klebsiella variicola strain F2R9 and Vibrio alginolyticus strain ATCC 17749. NRPS genes from 3 potential isolates were not successfully detected. The presence of PKS-1 and NRPS genes from isolates whose species names are known can be traced using the antiSMASH database which can be accessed via https://antismash-db.secondarymetabolites.org/browse based on the taxa of the related bacterial species.

Figure 6 PKS-1 gene detection from Bacillus paramycoides strain MCCC 1A04098 (1), Klebsiella variicola strain F2R9 (2), Vibrio alginolyticus strain ATCC 17749 (3), and 1 kb NA ladder (4).
Figure 7 shows the results of NRPS gene searches from Klebsiella variicola and Vibrio alginolyticus bacteria, both of which have NRPS genes in the hybrid region with NRP-metallophores. The difference is that the secondary metabolite product in K. varicolla is enterobactin while in V. alginolyticus is vanchrobactin. V. alginolyticus also has NRPS-independent lucA/lucC-like siderophores which are genes encoding vibrioferrin.

Figure 7 NRPS gene searches of Klebsiella variicola and Vibrio alginolyticus in AntiSmash database.
This figure shows the results of the biosynthetic gene cluster (BGC) similarity analysis for Klebsiella variicola strain CDC4241-71, as determined by the antiSMASH platform. The 1st information from Figure 7 is that Klebsiella variicola species likely share the same NRPS gene as Klebsiella variicola CDC4241-71 found on the antiSMASH platform. The following is a description of the gene cluster of Klebsiella variicola CDC4241-71. Gene region: 1.1; type: Hybrid region consisting of non-ribosomal peptide metallophore and non-ribosomal peptide synthase NRPS); nucleotide positions 1,817,971 to 1,871,849 in the genome; Edges: “No” (indicating the BGC does not touch the edge of the contig, implying the cluster is most likely complete); Most similar MIBiG cluster: Enterobactin. Similarity: 100% (indicating a perfect match to known BGCs in the MIBiG database)
The 2nd information is that Vibrio alginolyticus species likely share the same gene cluster as Vibrio alginolyticus ATCC 17749 (Figure 7). Gene cluster region: 1.2; Type: Hybrid region consisting of non-ribosomal metallophore peptide and non-ribosomal synthase peptide (NRPS), Nucleotide positions 893,644 to 952,478; Edge: “No” (indicating the cluster is not on the edge of a contig, so it is most likely intact); MIBiG cluster most similar: Vanchrobactin; Similarity: 100% (perfect match to known MIBiG cluster) MIBiG BGC ID: BGC0000454.
In addition to the Vanchrobactin gene cluster, Vibrio alginolyticus ATCC 17749 also has another gene cluster that encodes vibrioferin located in region: 2.1 with type: NRPS-independent siderophore, lucA/lucC-like type; Genome Location (From - To): 339.249 - 372.095, Edge: No (cluster not on contig edge → most likely complete); MIBiG Cluster Similarity: Vibrioferrin; Similarity Level: 100% MIBiG BGC ID: BGC0000947.
The test bacteria used in this study were MDR bacteria obtained from Kariadi General Hospital Semarang, including S. aureus, E. coli, and P. aeruginosa. The selection of the test bacteria was based on the availability of MDR cultures at Kariadi General Hospital isolated from patients. MDR bacterial infections mostly caused by Gram-positive bacteria such as S. aureus, S. pneumonia, E. faecium, and E. faecalis, while the Gram-negative group caused by A. baumannii, E. coli, P. aeruginosa, and K. pneumonia [18]. MDR bacteria can be formed due to improper use of antibiotics that trigger the formation of resistant genes (vertical transmission) or the acquisition of resistant genes through bacterial conjugation (horizontal transmission) [19]. MDR bacterial infection raises problems in determining and limiting the right type of antibiotic, so it is necessary to explore new antibiotic candidates. Tunicates and their associated bacteria have the potential to produce bioactive compounds with antibacterial properties. [20] wrote that associated microbes can synthesize the same secondary metabolites as their hosts. The potential of tunicates association bacteria as producers of antibacterial compounds has been successfully reported, including Microbulbifer sp. producing Bulbiferates A and B [21], Pseudoalteromonas rubra producing isatin which can inhibit Bacillus cereus, B. megaterium, E. coli, Micrococcus luteus [9], Streptomyces sp. produces Granaticin, granatomycin D, and dihydrogranaticin B [22], and Talaromyces sp. produces talaropeptides A and B inhibiting B. subtilis [23].
The results of sensitivity testing of MDR bacteria to various antibiotics (Appendix 1) by the microbiology laboratory of Dr. Kariadi Hospital Semarang showed that S. aureus was resistant to 9 out of 16 antibiotics tested and identified as Methicilin Resistant Staphylococcus aureus (MRSA). E. coli was resistant to 13 out of 22 antibiotics tested and identified as ESBL (extended-spectrum beta-lactamases) producing E. coli. P. aeruginosa was resistant to 8 antibiotics tested, identified as P. aeruginosa MDR. Bacterial resistance testing against antibiotics is carried out based on the minimum inhibitory concentration (MIC). MIC is the lowest concentration of antibacterial agent expressed in mg/L (µg/L), strictly controlled under in vitro conditions that completely prevent the growth of a test strain of an organism [24]. MIC has similarities with ZOI in qualitative methods, namely the interpretation of the sensitivity and resistance of the pathogen to the given antibiotic.
The agar plug method begins with the preparation of a culture that is tightly streaked on the agar surface. During incubation, bacterial cells will secrete molecules that diffuse in the agar medium, then the agar piece is transferred to the surface of the agar previously inoculated with test bacteria. The molecules in the agar piece will diffuse into the test medium. The antimicrobial activity of the bacterial-secreted molecules is detected by the appearance of a zone of inhibition around the agar [25]. Unlike the MIC, the concentration and type of antibacterial compounds that diffuse into the agar in the agar plug method are not measurable. Based on the antagonistic test of 81 isolates of tunicates association bacteria against 3 MDR bacteria, 25 isolates were obtained that have antibacterial activity, namely the formation of inhibition zone (Figure 1). The diameter of the inhibition zone or ZOI (Zone of Inhibition) is categorized as weak if the diameter is 7 - 11 mm, moderate if the ZOI is 12 - 16 mm, strong if the ZOI is 17 - 21, and very strong if the ZOI is ≥ 21 mm [9]. The results of the inhibition zone measurements are shown in Table 1. Based on the results of antibacterial testing, only 2 of the 25 isolates showed a weak ZOI category, namely isolates KJ2Z411-04 (10 mm against S. aureus; 8.4 mm against E. coli) and KJ2Z318-01 (7.8 mm against S. aureus), while the rest formed a very weak ZOI of less than 7 mm.
Based on microscopic observations, isolate KM402-02 is Gram-negative bacillus-shaped, isolate KJ2Z411-04 is Gram-negative short bacillus-shaped (slightly curved), and isolate KJ2Z411-01 is Gram-positive bacillus-shaped. All 3 potential isolates showed the highest inhibitory activity against gram-positive mdr bacteria S. aureus compared to gram-negative MDR E. coli and P. aeruginosa. Gram-negative bacteria become more resistant to Gram-positive bacteria due to the presence of membrane lipopolysaccharide (LPS) [18]. Changes in the structure of the outer membrane, mutations in porin channels, or an increase in hydrophobic properties lead to the development of gram-negative bacterial resistance [40]. Molecular identification is carried out to determine the species of potential bacterial isolates based on the 16S rRNA gene. The 16S rRNA gene is about 1,500 bp long, consisting of a conserved nucleotide sequence, interspersed with 9 specific variable regions, so it can detect DNA from any bacterial species [26]. The nucleotide sequence of the 16S rRNA gene sequencing results was aligned using Mega 11 software and then analyzed using BLAST (Basic Local Alignment Search Tool) nucleotides on NCBI. This program is used to compare nucleotide sequences with sequence data in the GenBank and determine the statistical significance of matches [27]. Anwar et al. [28] added that BLAST can be used to identify sequences, find target DNA efficiently, infer gene function, and predict domain architecture of the protein structure, and primer design. Based on BLAST search, it is known that isolate KM402-02 has nucleotide base sequence similarity with Klebsiella variicola by 99.20%, isolate KJ2Z411-04 is Vibrio alginolyticus with homology 99.86%, and isolate KJ2Z318-01 is Bacillus paramycoides with homology 99.86%. The kinship of potential isolate species with other bacteria can be known by phylogenetic tree construction (Figure 7). Homology ≥ 99% is identified as the same species, while 16S rRNA sequence homology < 98% tends to be grouped into 1 genus or 1 taxon level above [29].
Klebsiella variicola is a Gram-negative bacterium, non-motile bacillus, facultative anaerobe, found in various natural habitats, and some strains can be pathogenic [30]. Research related to the use of K. variicola shows that the bacteria can be used in agriculture and contribute to the development of microbial fertilizers suitable for saline-alkali areas [31]. The results of the antibacterial activity test of K. variicola against MDR bacteria in this study showed new findings. Vibrio alginolyticus is known as an opportunistic pathogenic bacterium causing disease in animals and humans, but V. alginolyticus associated with marine invertebrates can have antibacterial activity. Nursyam [32] successfully isolated V. alginolyticus from Haliclona sp. sponge samples that showed antibacterial activity against S. aureus. The findings in this study showed the activity of V. alginolyticus in inhibiting MDR E. coli and S.aureus bacteria. Utilization of K. variicola and V.alginolyticus as a source of anti-MDR compounds can be done by extraction of secondary metabolites to avoid possible pathogenicity of the 2 isolates. Bacillus paramycoides can be applied as a bioremediation agent because it can produce different enzymes such as cellulase, protease, and amylase at 1 time [33]. The findings in this study showed that B. paramycoides was able to inhibit S. aureus and E. coli. This finding is similar to the research of Trianto et al. [34], namely B. paramycoides symbiont Sponge can inhibit Methicilin Resistant Staphylococcus aureus (MRSA).
Phylogenic tree construction was used to determine the species-relatedness of potential isolates. The phylogenetic tree was constructed using the neighbor-joining method to provide the best estimate of the length of the closest branch that reflects the distance between sequences [35] and then statistically tested using a bootstrap of 1,000 replicates to test the topological validity of the phylogenetic tree [36]. Bootstrap is categorized as strong if > 85%, moderate 70% - 85%, weak 50% - 70%, and poor < 50% [37]. The results of phylogeny tree construction show bootstrap with strong validity. Isolate KM402-02 is K. variicola strain F2R9 with bootstrap 98, closely related to K. pneumoniae strain DSM 30104 with bootstrap 89. Isolate KJ2Z411-04 is V. alginolyticus strain ATCC 17749 with bootstrap value 100, closely related to V. natriegens NBRC 15636 with bootstrap 99. Isolate KJ2Z318-01 is B. paramycoides strain MCCC 1A04098 with bootstrap value 97.
The success of PKS-1 and NRPS gene detection is influenced by the PCR conditions during gene amplification. The DNA polymerase enzyme will attach and add complementary nucleotide bases to the DNA band affixed by the primer. PCR requires an optimum temperature in a primer attachment (annealing temperature) that is adjusted to the levels of nitrogenous bases that make up the primer. Melting temperature (Tm) is used as annealing temperature optimization. Amplification of the PKS-1 gene used primers K1F (Tm = 55.7 C) and M6R (Tm = 59.4 C), while the NRPS gene used primers A3F (Tm = 62.3 C) and A7R (Tm = 62.4 C. Adjustment of the annealing temperature ± 5 C below to above Tm was done to increase the chance of amplification of PKS-1 and NRPS genes.
Polyketides (PK) and non-ribosomal peptides (NRP) are microbial secondary metabolites that can help microbes adapt to the environment and withstand stressful environmental conditions [38]. [39] explained that PKS and NRPS consist of several catalytic domains arranged in several modules where each module performs a chain-lengthening cycle and usually contains at least 3 domains, namely keto synthase (KS), acyltransferase (AT), and acyl carrier protein (ACP) domains in the PKS module, as well as condensation (C), adenylation (A), and thiolation (T) domains in the NRPS module. The domains in the modules modify chemically elongated chains, synthesized from simple building blocks such as acyl-CoA and amino acid units by the PKS and NRPS gene clusters. Therefore, the chemical structure of the synthesized polyketides and/or peptides can be predicted from the arrangement of the domains of these clusters. The detection of PKS-1 and NRPS genes can be used as an initial step in genome mining to deepen the potential of bacterial isolates in forming secondary metabolites according to their metabolite pathways. Based on Figure 6. PKS-1 gene was successfully detected in 2 potential isolates, namely K. variicola strain F2R9 and V. alginolyticus strain ATCC 17749.
NRPS genes from potential bacteria have not been successfully detected. The identification results of potential bacterial species can be used to trace the presence of NRPS genes through the antiSMASH database browse by taxa. Taxa from bacteria were used to browse and compare data in the antiSMASH database. Taxa from Bacillus paramycoides were not found in the antiSMASH database so NRPS gene tracing could not be done. Taxa search results from Klebsiella variicola strain F2R9 and Vibrio alginolyticus strain ATCC 17749 showed the presence of the NRPS gene (Figure 7). This analysis identified a biosynthetic gene cluster (BGC) in Klebsiella variicola that showed 100% similarity to a previously characterized enterobactin cluster (MIBiG ID: BGC0002476). The identified region (Region 1.1) covers approximately 54 kb and is classified as a hybrid cluster containing non-ribosomal peptide synthase (NRPS) enzymes and metallophores. Enterobactin is a siderophore with high affinity for iron that is commonly produced by Enterobacteriaceae bacteria to acquire iron under iron-deficient environmental conditions [41]. This high similarity with enterobactin BGC indicates that K. variicola has a high possibility of producing enterobactin compounds. This ability may contribute significantly to the survival and competition of these bacteria in iron-deficient environments, such as within the host. The presence of such siderophore systems is also often associated with the pathogenic properties and competitiveness of microbes in ecosystems [42]. Interestingly, this cluster is not at the edge of a contig, so it is likely that the genetic region is complete and can be further analyzed for functional and comparative studies. Therefore, K. variicola could be a potential model to study enterobactin biosynthesis and regulation in Klebsiella species.
The biosynthetic gene cluster identified in Vibrio alginolyticus showed 100% similarity to the previously characterized vanchrobactin cluster (BGC ID: BGC0000454). Vanchrobactin is a type of siderophore, which is a small molecule produced by bacteria to bind and transport iron ions from the surrounding environment, especially under iron deficiency conditions [43]. The region of this cluster covers about 59 kb and belongs to the hybrid category between metallophore peptides and non-ribosomal peptide synthases (NRPS), which is a common feature in siderophore biosynthesis. The high similarity with the vanchrobactin cluster indicates that V. alginolyticus is most likely capable of producing vanchrobactin compound molecules. The ability to produce vanchrobactin may provide an ecological and pathogenic advantage for V. alginolyticus, especially since siderophores play an important role in microbial competition and virulence [44]. Siderophores allow the bacteria to survive in marine environments that tend to have low iron concentrations, as well as support infectivity if these bacteria interact with host organisms. In the field of natural products, vanchrobactin has cytotoxic activity against leukemia cancer cells [45]. The fact that this cluster is not on the edge of the contig indicates that the sequence is complete, so it can be a target for further studies regarding the regulation of gene expression, biosynthetic potential, and its application in the field of marine biotechnology or the development of antimicrobial agents.
In addition to vanchrobactin, the results of Vibrio alginolyticus BGC analysis with the antiSMAH platform also found the existence of a gene cluster that plays a role in the biosynthesis of vibrioferrin, which is a type of siderophore (iron-binding compound) produced through an independent pathway from NRPS (Non-Ribosomal Peptide Synthetase) [46]. Siderophores such as vibrioferrin are essential for the survival of marine microorganisms, as they help bacteria acquire iron from environments that naturally have very low iron availability. Vibrioferrin works by strongly binding to Fe³⁺ ions, then the complex is transported into the bacterial cell through a specialized transport system [47]. The specialty of vibrioferrin is that it is synthesized via the lucA/lucC-like pathway, which is an alternative mechanism of siderophore biosynthesis to the more common NRPS pathway. This pathway tends to be more energy efficient and consists of typical enzymes that can be identified in this gene cluster [44]. The 100% similarity to the vibrioferrin cluster documented in the MIBiG database (BGC0000947) suggests that this cluster in V. alginolyticus is highly conservative and functionally and structurally identical. This supports the assumption that V. alginolyticus ATCC 17749 is actively producing vibrioferrin, which reinforces its potential in environmental adaptation and its possible contribution to virulence if it invades the host. As this cluster is not at the end of a contig, it can be assumed that its genetic information is complete. This is very important for further analysis, both for genetic engineering, biosynthesis of secondary metabolites, as well as for the exploration of biotechnological applications, such as the production of siderophores for agriculture (increased iron uptake in plants) or the development of pathogenic microbial growth inhibitor systems (competitive antagonism).
Conclusions
The antibacterial test results obtained 3 potential isolates namely KM402-02, KJ2Z411-04, and KJ2Z318-01. 16S rRNA gene analysis showed that isolate KM402-02 is Klebsiella variicola Strain F2R9, KJ2Z411-04 is Vibrio alginolyticus Strain AATC 17749, and KJ2Z318-01 is Bacillus paramycoides. The PKS-1 gene was successfully detected in isolates KM402-02 and KJ2Z411-04
Acknowledgements
This research is fully funded by the Ministry of Higher Education and Research under the scheme National Competitive Basic Research with contract number National Competitive Program and Assignment in Higher Education in 2022 with Number: 088/ES/PG.02.00.PT /2022 and the derived contract number: 345-07/UN7.6.1/PP/2022.
Declaration of Generative AI in Scientific Writing
The authors acknowledge the use of generative AI tools in the preparation of this manuscript, specifically for language editing and grammar correction. No content generation or data interpretation was performed by AI. The authors take full responsibility for the content and conclusions of this work.
CRediT Author Statement
Robby Maulana Putra: Methodology, Investigation, Formal analysis, Validation, Visualization, Writing-original draft
Diah Ayuningrum: Conceptualization, Supervision, Validation, Funding acquisition, Resources, Project administration, and Writing-Review & Editing
Aninditia Sabdaningsih: Conceptualization, Supervision, Validation, Funding acquisition, Resources and Project administration.
Atika Arifati: Formal analysis, Validation, Visualization, and data curation
References
[1] ER Utami. Antibiotics, resistance, and rationality of therapy. El-Hayah Jurnal Biologi 2011; 1(4), 3.
[2] S Cesur and AP Demiroz. Antibiotics mechanism of resistance to antibiotics. Medical Journal of Islamic World Academy of Sciences 2013; 21(4), 138-142.
[3] JR Wartu, AQ Butt, U Suleiman, M Adeke, FB Tayaza, BJ Musa and J Baba. Multidrug resistance by microorganisms: A review. Science World Journal 2019; 14(4), 49-56.
[4] MM Khoeri, OK Radjasa and A Sabdono. Bioprospecting of bacterial symbiont of tunicate Didemnum mole from Sambangan, Karimunjawa Islands. Journal of Coastal Development 2011. 14(3), 255-261.
[5] Q Song, XM Li, XY Hu, X Li, LP Chi, HL Li and BG Wang. Antibacterial metabolites from ascidian-derived fungus aspergillus clavatus AS-107. Phytochemistry Letters 2019; 34, 30-34.
[6] A Bauermeister, PC Branco, LC Furtado, PC Jimenez, LVC Lutovo and TMC Lutovo. Tunicates: A model organism to investigate the effects of associated-microbiota on the production of pharmaceuticals. Drug Discovery Today: Disease Models. 2019; 28, 8.
[7] C Ramesh, BR Tulasi, M Raju, N Thakur and L Dufosse. Marine natural products from tunicates and their associated microbes. Marine Drugs 2021; 19(6), 308.
[8] S Flock, S Antonsen, HG Smith, AM Langseter, L Skattebol and Y Stenstrom. The first synthesis of crucigasterin 227- a polyunsaturated C-18 amino alcohol from the mediterranean tunicate pseudomonas crucigaster. Tetrahedron 2016; 72(30), 4518-4522.
[9] D Ayuningrum, Y Liu, Riyanti, MT Sibero, R Kristiana, MA Asagabaldan, ZG Wuisan, A Triyanto, OK Radjasa, A Sabdono and TF Scaberle. Tunicate-associated bacteria show a great potential for the discovery of antimicrobial compounds. PLoS One 2019; 14(3), e0213797-e0213797.
[10] DAA Farraj, R Varghese, C Vagvolgyi, MS Elshikh, AM Alokda and AH Mahmoud. Antibiotics production in optimized culture condition using low-cost substrates from streptomyces sp. AS4 isolated from mangrove soil sediment. Journal of King Saud University-Science. 2020; 32(2), 1528-1535.
[11] A Ayuso-Sacido and O Ganilloud. New PCR primers for the screening of NRPS and PKS-I systems in actinomycetes: Detection and distribution of these biosynthetic gene sequences in major taxonomic groups. Microbial Ecology 2004; 49(1), 10-24.
[12] S Romano, SA Jackson, S Patry and ADW Dobson. Extending the one strain many compounds (OSMAC) principle to marine microorganism. Marine Drugs 2018; 16(7), 244.
[13] RM Putra, D Ayuningrum and A Sabdaningsih. Isolation and morphological characterization of tunicate-associated bacterial colonies from the shipwreck of Kumbang Karimunjawa, Jepara, Indonesia. International Journal of Research Publication and Reviews 2024; 5(6), 446-453.
[14] D Ayuningrum, R Kristiana, AA Nisa, SK Radjasa, SI Muchlissin, OK Radjasa, A Sabdono and A Triyanto. Bacteria associated with tunicate, policarpa aurata, from Lease Sea, Maluku, Indonesia exhibiting anti-multidrug resistant bacteria. Biodiversitas Journal of Biological Diversity 2019; 20(4), 956-964.
[15] HJ Benson. Microbiological application 8th edition. McGraw Hill, New York, 2001, p. 64-203.
[16] A Sabdaningsih, O Cristianawat, MT Sibero, M Aini, OK Radjasa, A Sabdono and A Triyanto. Anti-MDR Acinetobacter baumannii of the sponges-associated fungi from Karimunjawa National Park. AACL Bioflux 2019; 12(5), 1970-1983.
[17] AA Tomaseto, MC Alpiste, AFC Nassar and SAL Destefano. Antibacterial activity of phytopathogenic streptomyces strains against bacteria associated to clinical diseases. Arquivos do Instituto Biologico 2020; 87(1-7), e0142020.
[18] A Bharadwaj, A Rastogi, S Pandey, S Gupta and JS Sohal. Multidrug-resistant bacteria: Their mechanism of action and prophylaxis. BioMed Research International 2022; 2022(3), 1-17.
[19] SS Noer, R Yulia, F Herawati and A Zamroni. Analysis of antibiotic use in neurosurgery patients in the ICU room of Dr. Sosodoro Djatikoesoemo Bojonegoro hospital. Syntax Literate: Indonesian Scientific Journal 2022; 7(7), 9037-9052.
[20] D Wulandari, LH Amatullah, AT Lunggani, AR Pratiwi and A Budiharjo. Antibacterial activity and molecular identification of soft coral Sinularia sp. symbiont bacteria from karimunjawa island against skin pathogens propionibacterium acnes and staphylococcus epidermidis. BIO Web of Conferences 2024; 92, 02001.
[21] DR Jayanetti, DR Braun, KJ Barns, SR Rajski and TS Bugni. Bulbiferates A and B: Antibacterial Acetamidohydroxybenzoates from a marine proteobacterium, Microbulbifer sp. Journal of Natural Products 2019; 82(7), 1930-1934.
[22] AA Sung, SM Gromek and MJ Balunas. Upregulation and identification of antibiotic activity of a marine-derived Streptomyces sp. via co-cultures with human pathogens. Marine Drugs 2017; 15(8), 250.
[23] P Dewapriya, ZG Khalil, P Prasad, AA Salim, PC Morales, E Marcellin and RJ Capon. Talaropeptides A-D: Structure and biosynthesis of extensively N methylated linear peptides from an Australian marine tunicate-derived Talaromyces sp. Frontiers in Chemistry 2018; 6, 394.
[24] BK Krochmal and RD Wicher. The minimum inhibitory concentration of antibiotics: Methods, interpretation, clinical relevance. Pathogens 2021; 10(2), 165.
[25] M Balouiri, M Sadiki and SK Ibnsouda. Methods for in vitro evaluating antimicrobial activity: A review. Journal of Pharmaceutical Analysis 2016; 6(2), 71-79.
[26] D Sune, H Rudberg, AN Augustinsson, L Serrander and MB Jungestrom. Optimation of 16S rRNA gene analysis for use in the diagnostic clinical microbiology service. Journal of Microbiological Methods 2020; 170(4), 105854.
[27] S Suprianto, IM Budiarsa and F Dhafir. Studi in silico: Hasil BLAST gen clock pada megapodiidae. Jurnal Riset Sains dan Teknologi 2022; 6(1), 33.
[28] MA Anwar, S Nurjanah and WP Rahayu. Aplikasi basic local alignment search tool (BLAST) NCBI pada Penelitian Molekuler Salmonela spp. Syntax Literate: Jurnal Ilmiah Indonesia 2022; 7(11), 15446.
[29] MA Syah. Isolation and molecular characterization of 16S rRNA gene of lipolytic bacteria from cashew seed shell waste. Journal of Biological Resources 2022; 8(1), 20-26.
[30] NR Medina, HB Camacho, JD Bedolla and UG Ramoz. Klebsiella variicola: An emerging pathogen in humans. Emerging Microbes & Infection 2019; 8(1), 973-988.
[31] L Yang and K Yang. Biological function of klebsiella variicola and its effect on the rhizosphere soil of maize seedlings. PeerJ 2020; 8, e9894.
[32] H Nursyam. Antibacterial activity of metabolites product of vibrio alginolyticus isolated from sponge Haliclona sp. against staphylococcus aureus. Italian Journal of Food Safety 2017; 6(1), 6237.
[33] J Sarwan and JC Bose. Isolation, screening, and characterisation of bacillus paramycoides for producing cellulases, proteases and amylases from fabric industry. Research Square 2022. https://doi.org/10.21203/rs.3.rs-1700944/v1
[34] A Trianto, OK Radjasa, A Sabdono, SI Muchlissin, R Afriyanto, S Sulistiowati, SK Radjasa, P Crews and E Mccauley. Exploration culturable bacterial symbionts of sponges from Ternate Island, Indonesia. Biodiversitas Journal of Biological Diversity 2019; 20(3), 776-782.
[35] NLPI Dharmayanti. Molecular phylogenetic: Organism taxonomy method based on evolution history. Wartazoa 2011; 21(1), 10.
[36] DA Lestari, R Azrianingsih and H Hendrian. Filogenetik Jenis-jenis Annonaceae dari Jawa Timur Koleksi Kebun Raya Purwodadi Berdasarkan coding dan non-coding sekuen DNA. Journal of Tropical Biodiversity and Biotechnology 2018; 3(1), 1-7.
[37] WJ Kress, LMP MacKechnie and KJ Williams. The phylogeny and a new classification of the ginger (Zingiberaceae): Evidence from molecular data. American Journal of Botany 2002; 89(10), 1682-1696.
[38] Y Wei, L Zhang, Z Zhou and X Yan. Diversity of gene cluster for polyketide and non-ribosomal peptide biosynthesis revealed by metagenomic analysis of the yellow sea sediment. Frontiers in Microbiology 2018; 9, 295.
[39] H Komaki and T Tamura. Polyketide synthase and Nonribosomal peptide synthetase gene cluster in type strains of the genus Phytohabitans. Life 2020; 10(11), 257.
[40] A Parmanik, S Das, B Kar, A Bose, GR Dwivedi and MM Pandey. Current treatment strategies against multidrug-resistant bacteria: A review. Current Microbiology 2022; 79(12), 388.
[41] A Kumar, S Chakravorty, T Yang, TA Russo, SM Newton and PE Klebba. Siderophore-mediated iron acquisition by Klebsiella pneumoniae. Journal of Bacteriology 2024; 206(5), e0002424.
[42] R Han, M Niu, S Liu, J Mao, Y Yu and Y Du. The effect of siderophore virulence genes entB and ybtS on the virulence of Carbapenem-resistant Klebsiella pneumoniae. Microbial Pathogenesis 2022; 171(3), 105746.
[43] M Balado, CR Osorio and ML Lemos. A gene cluster involved in the biosynthesis of vanchrobactin, a chromosome-encoded siderophore produced by Vibrio anguillarum. Microbiology 2006; 152(P12), 3517-3528.
[44] A Pramanik and RK Vibhuti. Molecular mechanism of iron transport systems in vibrio. Journal of Pure and Applied Microbiology 2022; 16(1), 116-129.
[45] M Sandy, A Han, J Blunt, M Munro, M Haygood and A Butler. Vanchrobactin and Anguibactin Siderophores Produced by Vibrio sp. DS40M4. Journal of Natural Products 2010; 73(6), 1038-1043.
[46] SA Amin, DH Green, FC Kupper and CJ Carrano. Vibrioferrin, an Unusual Marine Siderophore: Iron Binding, Photochemistry, and Biological Implications. Inorganic Chemistry 2009; 48(23), 11451-1148.
[47] WA Norfolk, C Shue, WM Henderson, DA Glinski and EK Lipp. Vibrio alginolyticus growth kinetics and the metabolic effects of iron. Environmental Microbiology 2023; 11(6), e0268023.
[48] A Darbandi, A Asadi, MM Ari, E Ohadi, M Talebi, MH Zadeh, AD Emamie, R Ghanavati and M Kakanj. Bacteriocins: Properties and potential use as antimicrobials. Journal of Clinical Laboratory Analysis 2022; 36(1), e24093.
[49] MT Sibero, OK Radjasa, KG Bondar, LMI Simbolon, L Meilana, D Ayuningrum. Antibacterial activity and phytochemical content of Holothuria atra from Panjang Island, Jepara, Indonesia. AIP Conference Prociding 2019; 2120(1), 080005.